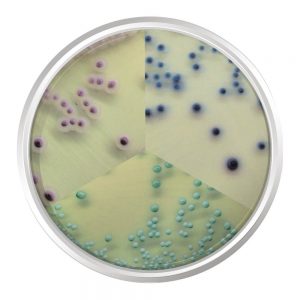

Entenda a microbiologia do leite: tipos de bactérias, riscos de contaminação e práticas para garantir a qualidade e segurança alimentar.
O que é a microbiologia do leite?
O leite é um alimento altamente nutritivo, rico em carboidratos, lipídios, proteínas de alto valor biológico, sais minerais e vitaminas essenciais. Essa composição faz do leite um ambiente ideal para a proliferação de diversos microrganismos, especialmente bactérias.
Nem todas as bactérias presentes no leite são prejudiciais à saúde humana; algumas são benéficas e ajudam a proteger contra microrganismos patogênicos que podem causar doenças.
No entanto, a ausência de controle adequado da atividade microbiana pode comprometer a qualidade do leite cru, tornando-o impróprio para o consumo.
Por isso, a legislação estabelece um limite máximo de 100 mil bactérias por mililitro de leite cru, garantindo a segurança alimentar e a proteção do consumidor. Devido à sua importância nutricional, o leite e seus derivados passam por rigorosos testes microbiológicos para assegurar a qualidade e a segurança do produto final.
Tipos de Bactérias
Diversos tipos de bactérias podem estar presentes no leite cru, e cada grupo tem impactos distintos na qualidade, segurança e validade do produto.
Os principais grupos são:
- Bactérias mesófilas
- Bactérias termodúricas
- Bactérias psicrotróficas
Além desses, também podem ser encontrados microrganismos patogênicos, coliformes e bactérias probióticas.
Compreender esses microrganismos é essencial para prevenir a contaminação do leite, evitar perdas na indústria e garantir a segurança alimentar do consumidor.
Bactérias Mesófilas
As bactérias mesófilas se desenvolvem com facilidade em temperaturas moderadas e são as primeiras a se multiplicarem quando o leite cru não é refrigerado corretamente após a ordenha.
Microrganismos como Lactobacillus, Streptococcus e Lactococcus são comuns nesse grupo e podem elevar rapidamente a acidez do leite, comprometendo seu valor comercial e dificultando seu uso na indústria de laticínios.
Fatores que favorecem o crescimento dessas bactérias incluem:
- Má higienização dos equipamentos de ordenha;
- Manuseio inadequado do leite;
- Ausência de resfriamento imediato após a ordenha.
A melhor forma de controlar bactérias mesófilas no leite é por meio da refrigeração rápida e eficiente, mantendo o produto em baixa temperatura até a pasteurização.
Bactérias Termodúricas
As bactérias termodúricas são microrganismos que resistem ao processo de pasteurização devido à sua capacidade de formar esporos altamente resistentes ao calor. Esses esporos permanecem viáveis no ambiente por anos, mesmo em condições adversas.
Os principais gêneros responsáveis por essa contaminação são Clostridium e Bacillus, ambos com espécies esporuladas que dificultam o controle microbiológico do leite.
A eliminação total dessas bactérias exige tratamentos térmicos mais intensos, como o aquecimento a 120 °C por cerca de 20 minutos — temperatura muito superior à utilizada na pasteurização convencional.
A presença elevada de bactérias termodúricas no leite indica falhas recorrentes na higienização dos equipamentos, como:
- Rachaduras em peças de borracha
- Acúmulo de resíduos sólidos (as chamadas “pedras de leite”) nas tubulações
- Ordenha de vacas com úberes sujos
Como sobrevivem ao tratamento térmico, essas bactérias afetam diretamente a validade do leite pasteurizado e de seus derivados, acelerando a deterioração do produto.
Bactérias Psicrotróficas
As bactérias psicrotróficas são microrganismos capazes de se multiplicar em temperaturas baixas, geralmente abaixo de 7 °C. Embora muitas sejam originalmente bactérias mesófilas, elas conseguem crescer lentamente durante o armazenamento refrigerado do leite cru.
Esse grupo representa um grande desafio para a indústria de laticínios, pois produz enzimas resistentes ao calor, como proteases e lipases, que permanecem ativas mesmo após a pasteurização.
Essas enzimas são responsáveis por:
- Degradação de proteínas e gorduras do leite
- Alterações no sabor e odor
- Redução da vida útil do produto
- Menor rendimento na produção de queijos
- geleificação do leite UHT
O crescimento dessas bactérias ocorre principalmente quando o leite cru refrigerado é armazenado por longos períodos — prática comum em sistemas de coleta a granel.
Altas contagens de psicrotróficas estão associadas a:
- Falhas na higiene durante a ordenha
- Limpeza inadequada dos equipamentos
- Refrigeração deficiente (temperaturas acima de 5 °C)
Embora muitas bactérias psicrotróficas não sejam patogênicas — como Pseudomonas, Aeromonas, Flavobacterium e Lactobacillus — algumas espécies podem causar doenças, como Listeria monocytogenes, Yersinia enterocolitica e Bacillus cereus, sendo responsáveis por intoxicações alimentares.
Microrganismo Patogénicos no Leite
O leite cru pode servir como meio de transmissão para diversos agentes patogênicos, capazes de causar doenças infecciosas em seres humanos. Entre os principais microrganismos que podem estar presentes no leite contaminado, destacam-se:
- Salmonella spp.
- Escherichia coli patogênica
- Listeria monocytogenes
- Campylobacter jejuni
- Yersinia enterocolitica
- Staphylococcus aureus
A maioria desses microrganismos é eliminada com o processo de pasteurização do leite, mas algumas bactérias termodúricas podem sobreviver ao tratamento térmico.
Além disso, existe o risco de contaminação pós-pasteurização, que pode ocorrer devido a:
- Equipamentos e utensílios mal higienizados
- Manipuladores contaminados
- Armazenamento inadequado após o processamento
Algumas bactérias, como o Staphylococcus aureus, produzem enterotoxinas resistentes ao calor. Nestes casos, o tratamento térmico pode eliminar as células bacterianas, mas não as toxinas, que continuam ativas e representam risco à saúde.
Há ainda microrganismos virais, como o vírus da febre aftosa, que não são completamente inativados pela pasteurização. A prevenção, nesse caso, depende da vacinação dos animais.
Patógenos mais recentemente identificados no leite, como Escherichia coli O157:H7 e Listeria monocytogenes, embora responsáveis por poucos surtos, preocupam devido à gravidade das doenças que podem causar, especialmente em grupos de risco como gestantes, idosos e imunossuprimidos.

Coliformes no Leite
A presença de coliformes no leite cru é considerada um importante indicador de contaminação fecal. Esse grupo de bactérias inclui principalmente os gêneros:
- Escherichia
- Enterobacter
- Klebsiella
Esses microrganismos são naturalmente encontrados no trato intestinal dos animais, e sua presença no leite está geralmente associada a falhas nas práticas de higiene.
Altas contagens de coliformes podem indicar:
- Ordenha realizada com má higienização dos úberes
- Uso de utensílios ou equipamentos contaminados
- Emprego de água imprópria para a limpeza
Embora alguns coliformes possam ser de origem ambiental, sua presença em níveis elevados sempre serve como um sinal de alerta. Isso indica a necessidade de revisar e aprimorar as boas práticas de ordenha, manejo e sanitização.
A detecção precoce desses microrganismos contribui para garantir a qualidade do leite cru e prevenir riscos à saúde do consumidor.
Probióticos
Os probióticos são microrganismos benéficos que desempenham papel fundamental na manutenção da saúde intestinal e na modulação do sistema imunológico. Eles estão presentes em produtos lácteos fermentados, como iogurtes, e incluem principalmente cepas dos gêneros:
- Lactobacillus
- Bifidobacterium
Esses microrganismos auxiliam na digestão, facilitam a absorção de nutrientes e competem com bactérias patogênicas como Salmonella typhimurium e Escherichia coli, reduzindo sua capacidade de colonização no trato gastrointestinal.
Além disso, os probióticos promovem o aumento da produção de imunoglobulina A (IgA), fortalecendo a resposta imune adaptativa do organismo.
Estudos indicam que a presença de Lactobacillus em lactentes está associada a um menor risco de alergias alimentares na vida adulta. Já a suplementação com Bifidobacterium em recém-nascidos durante o desmame pode diminuir a colonização por Bacteroides, reduzindo a chance de reações alérgicas.
Conclusão
A microbiologia do leite é essencial para garantir a segurança alimentar e a qualidade dos produtos lácteos. Embora o leite seja um ambiente ideal para o crescimento de diversos microrganismos, os riscos podem ser eficazmente controlados por meio de boas práticas de higiene na produção, refrigeração adequada do leite cru e processos de pasteurização eficientes.
Além de proteger a saúde do consumidor, o conhecimento detalhado sobre a microbiologia do leite contribui para a melhoria da cadeia produtiva e para o fortalecimento da saúde pública.
Referências
IFope. Microbiologia: entenda o processo de microbiologia do leite. Disponível em: https://blog.ifope.com.br/microbiologia/. Acesso em: 26 ago. 2025.
EMBRAPA. Tipos de microrganismos. Disponível em: https://www.embrapa.br/agencia-de-informacao-tecnologica/criacoes/gado_de_leite/pre-producao/qualidade-e-seguranca/qualidade/qualidade-higienica/microrganismos/tipos-de-microrganismos. Acesso em: 26 ago. 2025.
KASVI. Bactérias no leite: quais são e que cuidados exigem na produção. Disponível em: https://kasvi.com.br/bacterias-no-leite-quais-sao-e-que-cuidados-exigem-na-producao/. Acesso em: 26 ago. 2025.
